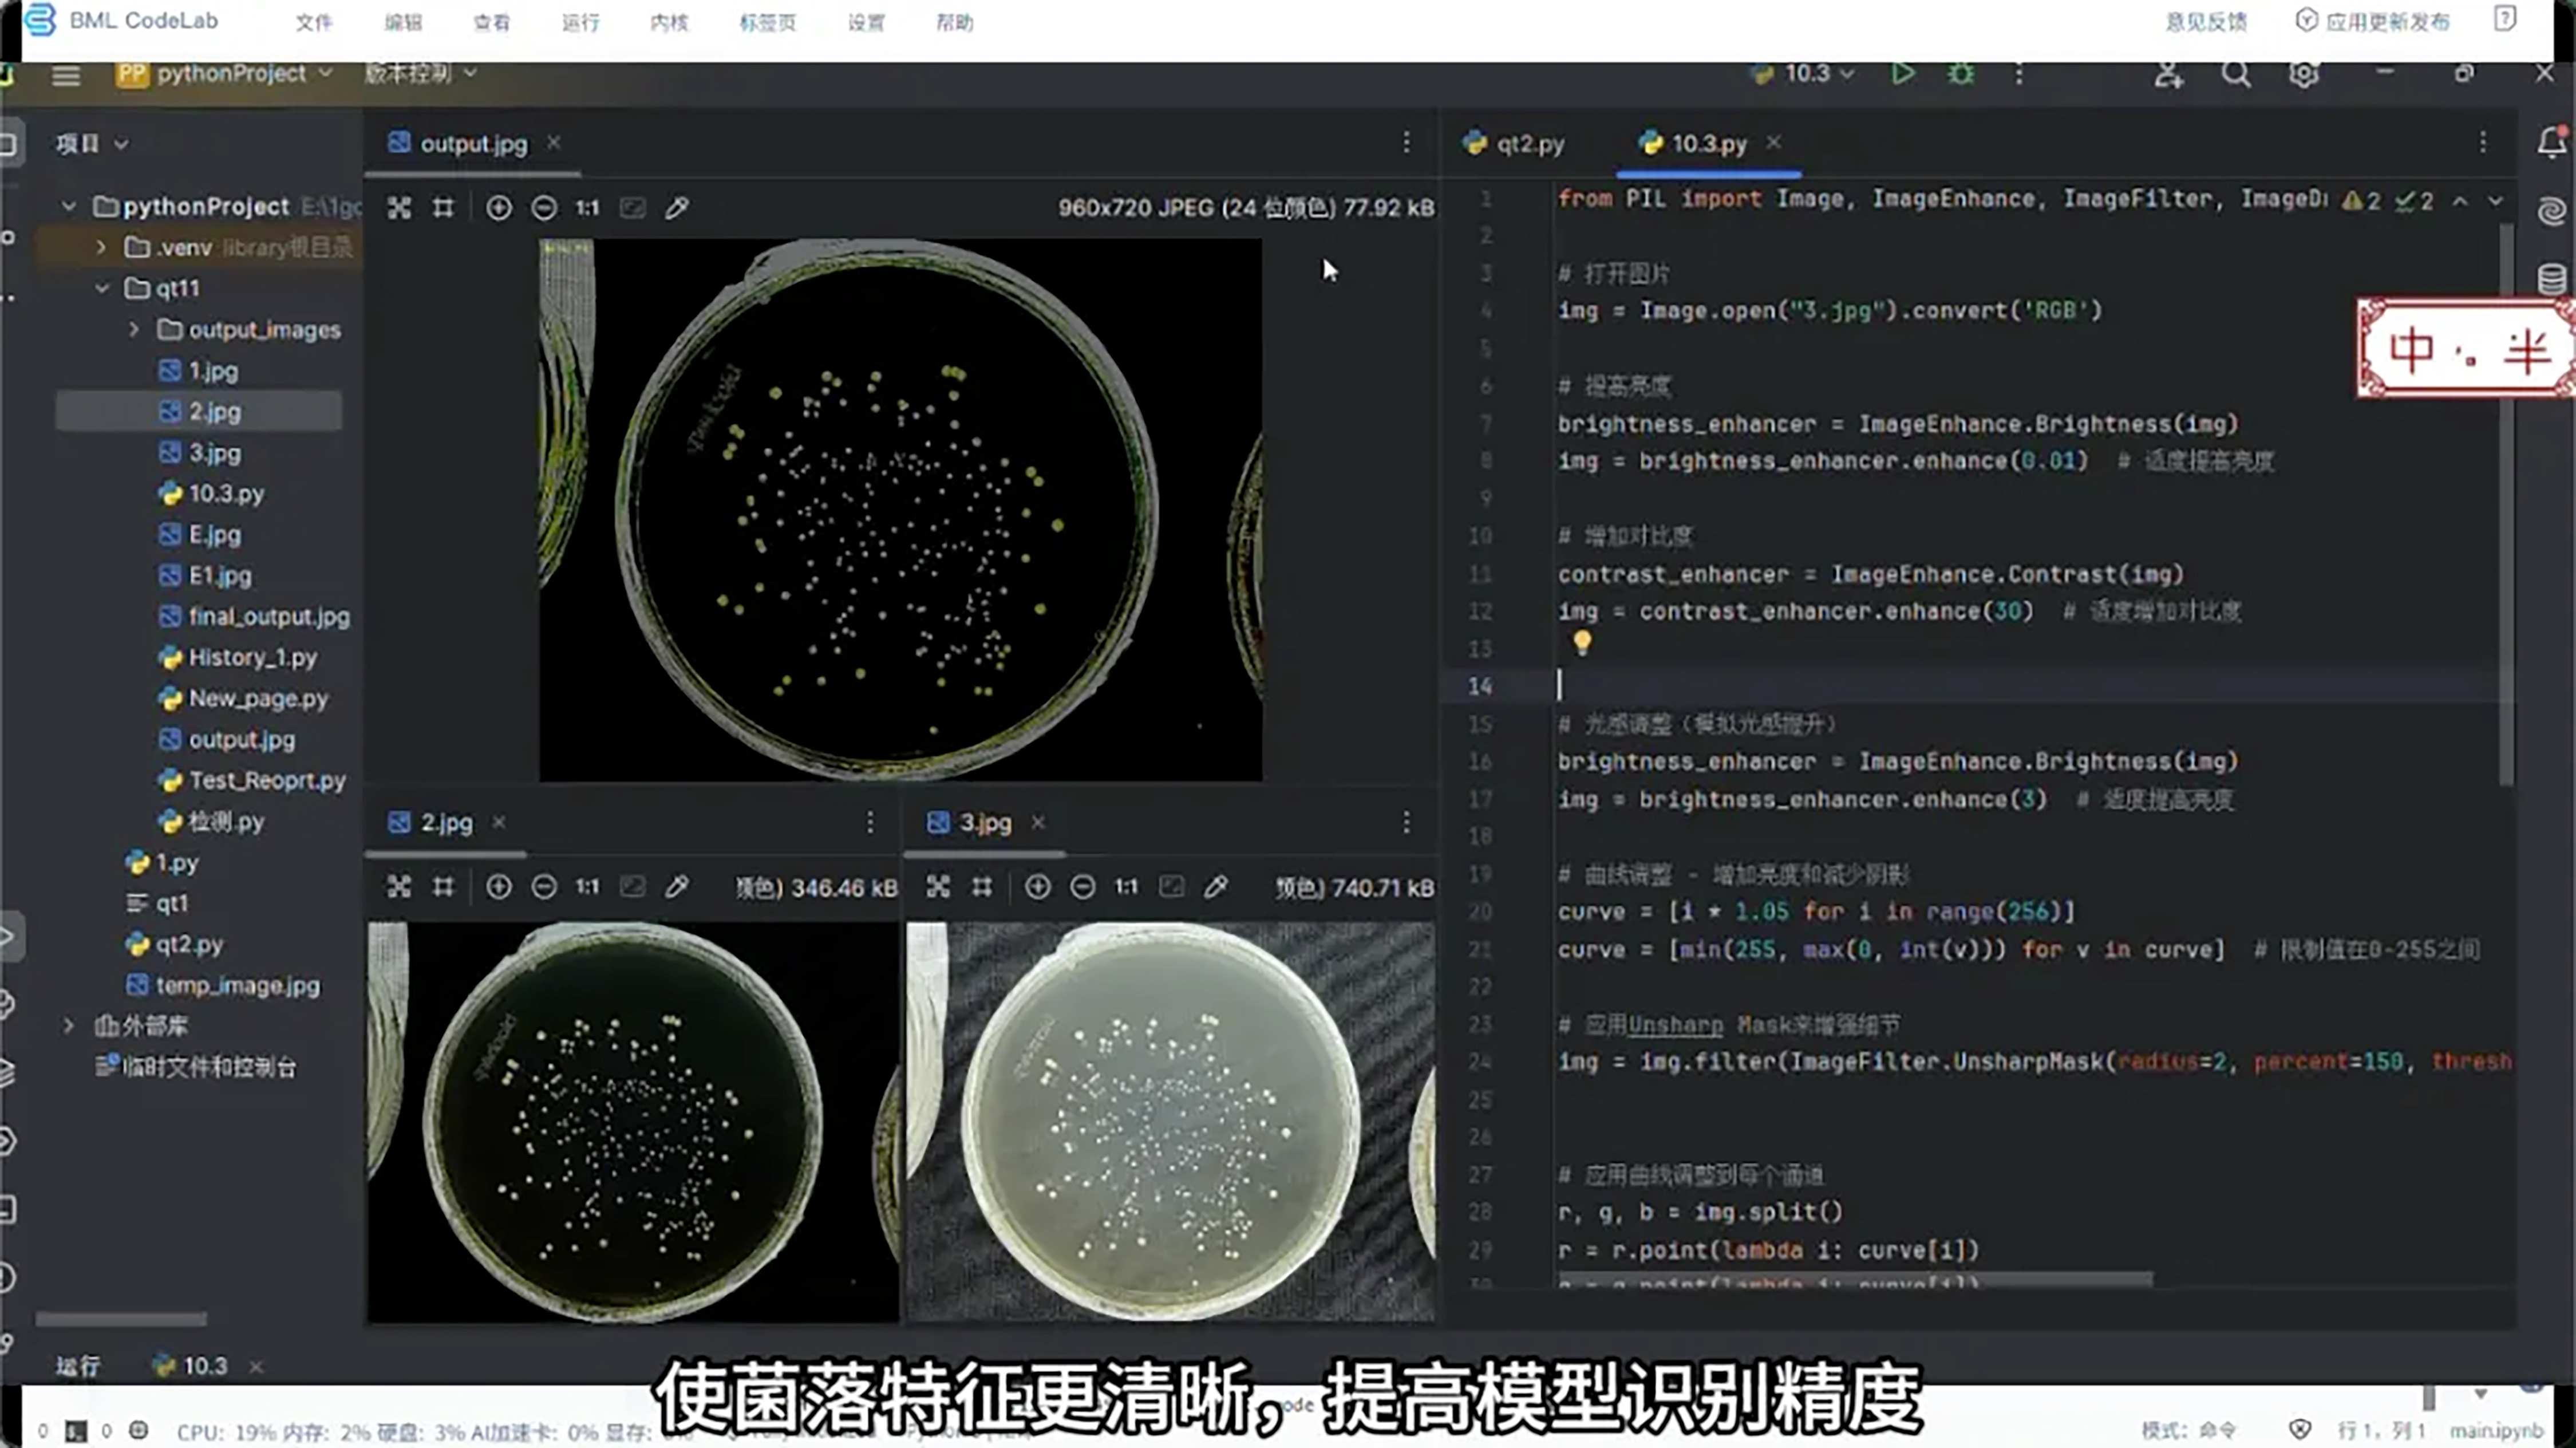

近日,由开放原子开源基金会与百度文心大模型联合主办的文心开源创新大赛 - AI硬件赛道正式落下帷幕。作为大赛硬件生态合作伙伴,此芯科技以搭载其通用智能处理器此芯P1的星睿O6开发套件,为多款获奖作品提供核心算力支持,助力AI大模型在边缘侧高效落地。

(图片来源:飞桨PaddlePaddle)
本次赛事聚焦“AI+硬件”前沿方向,依托文心大模型4.5的核心能力,吸引了众多海内外开发者踊跃参与,涌现出一批极具巧思与实用性的硬件原型与解决方案。在本次大赛中,基于此芯科技硬件平台的获奖作品覆盖科学检测、教育陪伴及AI工作站等真实场景,展现了该平台在多元场景中支撑复杂AI应用的广泛适用性与可靠性。

(图片来源:飞桨PaddlePaddle)
二等奖作品“微视睿鉴:基于文心大模型与边缘计算的菌落智能检测系统”,创新性地在搭载此芯P1芯片的边缘计算平台上,部署了经LoRA微调的ERNIE-4.5-21B-A3B模型,实现了高达99.76%的菌落识别准确率,单皿检测时间从5分钟压缩至5秒。

(图片来源:飞桨PaddlePaddle)
三等奖作品“Red Panda:儿童语言学习陪伴硬件”同样采用搭载此芯P1芯片的星睿O6开发套件为核心硬件平台。该项目实现了从端侧小模型(快速响应)到云端大模型(复杂逻辑)的无缝切换,配合动作、表情、声音的多模态反馈,打造了沉浸式的陪伴体验。


(图片来源:飞桨PaddlePaddle)
此外,荣获开源贡献奖的“ERNIE Desktop:开源可复现的AI工作站方案”与“EmoBird:基于共情理论的具身智能陪伴宠物鸟”项目,均基于此芯P1平台开发。通过极致的工程优化,ERNIE Desktop在Arm架构上成功运行ERNIE-4.5-21B-A3B (2-bit量化) 模型,实现了开箱即用、秒级启动以及15+TPS的流畅推理速度。EmoBird利用ERNIE-4.5强大的语义理解能力精准分析用户情绪,并将结果实时映射为EmoBird的肢体动作和声音反馈,探索了人机情感交互的新边界。

(图片来源:飞桨PaddlePaddle)
随着本届赛事圆满收官,边缘AI领域所迸发的创新活力与落地路径已愈发清晰。未来,此芯科技将持续深耕通用智能芯片设计与研发,携手全球开发者及产业伙伴,共同拓展智能技术的应用边界,推动AI创新在更广泛场景中实现规模化落地。

此芯P1赋能多元创新,助力开发者斩获文心开源创新大赛多项殊荣

咔嚓!此芯科技2025生态大会展区花絮大放送

万物共芯 · 生生不息——端侧AI开发者实践工作坊精彩收官

构筑智能底座,赋能产业未来:此芯科技2025生态大会技术论坛成功举办

万物共芯,生生不息:此芯科技2025生态大会共创开放智能未来

荣誉时刻 | 此芯科技荣登2025 openKylin社区年度技术贡献奖榜单

万物共芯 生生不息|此芯科技2025生态大会即将启幕

此芯科技携手生态伙伴实战演示文心大模型本地部署